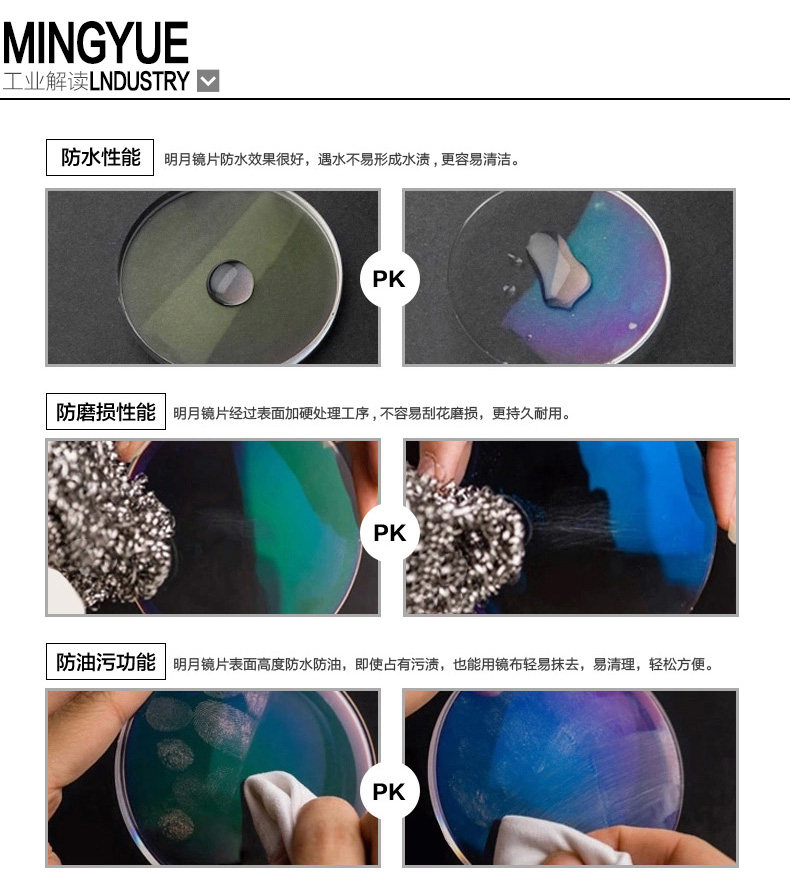

- Таобао
- Аксессуары
- Оптика
- Очки
- 553521916881
明月 Объектив, ультратонкие очки, 2 штук

Цена: 38 051руб. (¥1818)
Артикул: 553521916881
Вес товара: ~0.7 кг. Указан усредненный вес, который может отличаться от фактического. Не включен в цену, оплачивается при получении.
Описание товараPHA+PGltZyBjbGFzcz0iZGVzY19hbmNob3IiIGlkPSJkZXNjLW1vZHVsZS0xIiBzcmM9Imh0dHBzOi8vYXNzZXRzLmFsaWNkbi5jb20va2lzc3kvMS4wLjAvYnVpbGQvaW1nbGF6eWxvYWQvc3BhY2ViYWxsLmdpZiI+PHAgc3R5bGU9InRleHQtYWxpZ246IGNlbnRlcjsiPjxpbWcgYWxpZ249ImFic21pZGRsZSIgc3JjPSJodHRwczovL2ltZy5hbGljZG4uY29tL2ltZ2V4dHJhL2kyLzIzOTM5MTc4NzgvVEIyZVFla3RZSmtwdUZqeTF6Y1hYYTVGRlhhXyEhMjM5MzkxNzg3OC5qcGciPjxpbWcgYWxpZ249ImFic21pZGRsZSIgc3JjPSJodHRwczovL2ltZy5hbGljZG4uY29tL2ltZ2V4dHJhL2kyLzIzOTM5MTc4NzgvVEIyVm5oc3QzMGtwdUZqU3NwZFhYWDRZWFhhXyEhMjM5MzkxNzg3OC5qcGciPjxpbWcgYWxpZ249ImFic21pZGRsZSIgc3JjPSJodHRwczovL2ltZy5hbGljZG4uY29tL2ltZ2V4dHJhL2kyLzIzOTM5MTc4NzgvVEIyUndYRnQ0ZGtwdUZqeTBGYlhYYU5ucFhhXyEhMjM5MzkxNzg3OC5qcGciPjxpbWcgYWxpZ249ImFic21pZGRsZSIgc3JjPSJodHRwczovL2ltZy5hbGljZG4uY29tL2ltZ2V4dHJhL2kxLzIzOTM5MTc4NzgvVEIySDBSTXQ0WGxwdUZqU3NwaFhYYkpPWFhhXyEhMjM5MzkxNzg3OC5qcGciPjxpbWcgYWxpZ249ImFic21pZGRsZSIgc3JjPSJodHRwczovL2ltZy5hbGljZG4uY29tL2ltZ2V4dHJhL2kyLzIzOTM5MTc4NzgvVEIycjhwR3hZQm1wdUZqU1pGdVhYYUdfWFhhXyEhMjM5MzkxNzg3OC5qcGciPjxpbWcgYWxpZ249ImFic21pZGRsZSIgc3JjPSJodHRwczovL2ltZy5hbGljZG4uY29tL2ltZ2V4dHJhL2kyLzIzOTM5MTc4NzgvVEIybnEwemRuQUtoMUpqU1pGRFhYYktsRlhhXyEhMjM5MzkxNzg3OC5qcGciPjxpbWcgYWxpZ249ImFic21pZGRsZSIgc3JjPSJodHRwczovL2ltZy5hbGljZG4uY29tL2ltZ2V4dHJhL2kyLzIzOTM5MTc4NzgvVEIyeVdsdHg5MG1wdUZqU1pQaVhYYnNzVlhhXyEhMjM5MzkxNzg3OC5qcGciPjxpbWcgYWxpZ249ImFic21pZGRsZSIgc3JjPSJodHRwczovL2ltZy5hbGljZG4uY29tL2ltZ2V4dHJhL2k0LzIzOTM5MTc4NzgvVEIybE1oc3g0aG1wdUZqU1pGeVhYY0xkRlhhXyEhMjM5MzkxNzg3OC5qcGciPjxpbWcgYWxpZ249ImFic21pZGRsZSIgc3JjPSJodHRwczovL2ltZy5hbGljZG4uY29tL2ltZ2V4dHJhL2kzLzIzOTM5MTc4NzgvVEIyVjkwWHg1Um5wdUZqU1pGQ1hYWDJEWFhhXyEhMjM5MzkxNzg3OC5qcGciPjxpbWcgYWxpZ249ImFic21pZGRsZSIgc3JjPSJodHRwczovL2ltZy5hbGljZG4uY29tL2ltZ2V4dHJhL2kzLzIzOTM5MTc4NzgvVEIyWXE0bXhadG5wdUZqU1pGdlhYYmNUcFhhXyEhMjM5MzkxNzg3OC5qcGciPjwvcD48L3A+
Продавец:永乐眼镜专营店
Адрес:Цзянсу
Рейтинг:

Всего отзывов:0
Положительных:0
Выберите вариацию / цвет
- Два куска
Выберите размер / комплектацию
- 1,73 (ультра -тщательный)
Добавить в корзину
- Информация о товаре
- Фотографии
| Показатель преломления линзы: | 1,73 (ультра -тщательный) |
| Цвет: | Два куска |
| Липер подходящая степень: | В пределах 400 градусов, 400 градусов -650 градусов, 650 градусов -850 градусов, Выше 850 градусов |